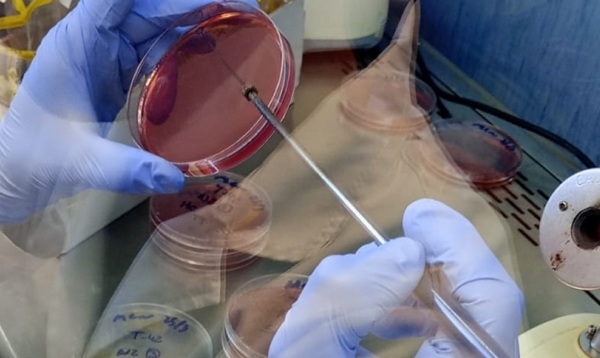
Argentina - INTA se integra a la RedLab para fortalecer el control sanitario avícola - Image 1
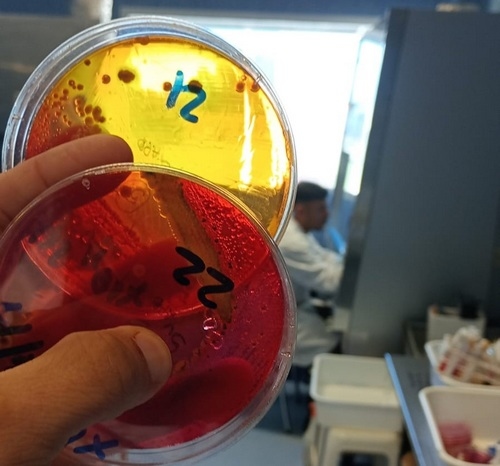
Argentina - INTA se integra a la RedLab para fortalecer el control sanitario avícola - Image 2

Argentina - INTA se integra a la RedLab para fortalecer el control sanitario avícola
Publicado: 27 de marzo de 2026
Por: Ministerio de Economía / Agricultura, Ganadería y Pesca / Senasa
Este paso garantiza análisis con validez oficial y estándares de calidad homogéneos. En esta primera etapa, quedó habilitado para detección de Salmonella spp.

La incorporación de la Unidad de Investigación Avícola (UIA) de la Estación Experimental Agropecuaria del INTA Concepción del Uruguay en la Red Nacional de Laboratorios del Servicio Nacional de Sanidad y Calidad Agrolimentaria (SENASA) implica cumplir con exigentes estándares vinculados a sistemas de calidad, buenas prácticas de laboratorio y competencias técnicas del personal, alineados a normativas nacionales e internacionales.
En esta primera etapa, el laboratorio quedó habilitado para el rubro de análisis de Salmonella spp., y ya se encuentra en proceso la incorporación de nuevos alcances. Se trata de un paso clave que fortalece la calidad y el reconocimiento de los análisis que allí se realizan.
El ingreso a la RedLab es el resultado de un trabajo sostenido de más de un año y medio, en el que se adecuaron procesos, se fortalecieron capacidades y en el que se consolidó un sistema de calidad robusto. Además, formar parte de la RedLab asegura estándares de calidad homogéneos en todo el país, fortalece el control de enfermedades y agiliza la gestión de muestras, lo que se traduce en respuestas más rápidas y confiables para el sector productivo y sanitario.

El reconocimiento no solo valida técnicamente los resultados que se generan, sino que también posiciona al laboratorio como un actor estratégico para acompañar al sector avícola con información confiable y con respaldo oficial.
Contar con la habilitación en el rubro de Salmonella spp. permite brindar respuestas analíticas rápidas y con reconocimiento del SENASA al sector avícola, teniendo en cuenta la importancia de esta producción en nuestra región.
El equipo ya trabaja en ampliar las capacidades avanzando en la validación de nuevos rubros, lo que permitirá ampliar la oferta de servicios del laboratorio y seguir acompañando las demandas del sector con estándares de calidad cada vez más altos.
La Red Nacional de Laboratorios del SENASA está integrada por instituciones públicas y privadas autorizadas para realizar ensayos y emitir resultados con validez oficial. La incorporación del laboratorio del INTA Concepción del Uruguay refuerza su compromiso con la excelencia técnica y su rol en el entramado sanitario-productivo del país.
“El ingreso a la RedLab es el resultado de un trabajo sostenido de más de un año y medio, en el que se adecuaron procesos, se fortalecieron capacidades y se consolidó un sistema de calidad robusto”, explicó a infobae Santiago Araujo, especialista en Bromatología del INTA Concepción del Uruguay y quien lideró el proceso.
Por su parte, Francisco Federico, responsable de la UIA y director técnico del laboratorio, destacó la importancia de contar con la habilitación para Salmonella spp., ya que permite brindar respuestas analíticas rápidas con reconocimiento del Senasa, especialmente en una región donde la producción avícola tiene un rol relevante.
Fuente
Ministerio de Economía / Agricultura, Ganadería y Pesca / SenasaTemas relacionados:
Mencionados en esta noticia:


Recomendar
Comentar
Compartir

¿Quieres comentar sobre otro tema? Crea una nueva publicación para dialogar con expertos de la comunidad.